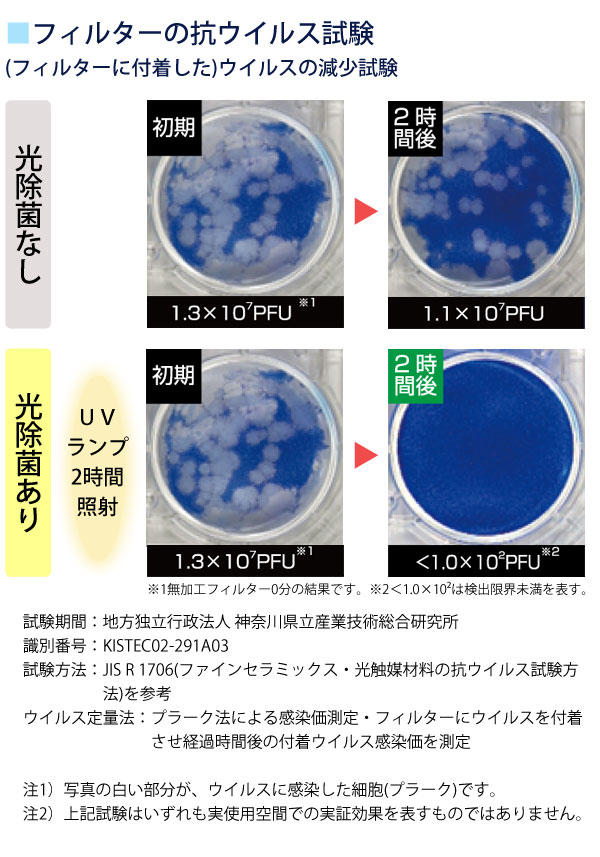
フィルターの抗ウイルス試験

【交換フィルター付き】空気清浄機 ブルーデオ M型〔MC-M102〕28畳用 空気消臭除菌装置【マスクフジコー】【送料無料】【いつでもポイント10倍】
132,000円(税込)
0ポイント(1%)
配送情報
お届け予定日:通常3〜6営業日以内に発送
※一部地域・離島につきましては、表示のお届け予定日期間内にお届けできない場合があります。ロットナンバー
579549126
商品説明

>>ブルーデオ関連商品一覧
光除菌のブルーデオのミドルサイズ!
リビングや会議室など広い空間の空気を、パワフルに消臭・除菌します。
これ一つで、約28畳用をカバーするので、リビングや会議室など広い場所もカバーすることが可能です。
ブルーデオM型は、タワー型ボディを採用した省スペースモデル。木目調のアクセントを施しているので、さまざまな空間に溶け込みます。
強力な消臭・除菌を実現する新開発4層フィルターユニットを装備!
「プレフィルター」、「HEPAフィルター」に加え、お手入れ不要な「脱臭フィルター」、「光除菌フィルター(紫外線LED搭載)」を装備!お手入れが必要なフィルターはお手入れ時期にランプが点灯してお知らせ。
元から分解するのでより安全
一般的な空気清浄機のフィルターは、菌やウイルス、臭いとなるガス成分を「吸着」させる方式ですが、ブルーデオは光触媒フィルターで「元から分解して除去」します。
何も出さないからより安心
オゾン、イオン、次亜塩素酸などの放出はゼロ。
有害因子を本体内部の光触媒フィルター上で分解・除去してキレイな空気でお部屋を満たします。
ワンボタンの簡単操作!
コンセントを差して、ボタンを押すだけ。ひとつのボタンで、電源ON/OFF、及び風量切り替えができます。
【よくある質問】
Q.以前のMC-M101にHEPAフィルター(品番:MC-M1HP01)を付けることができますか?
A.フィルターサイズが同じなため付けることができます。また、HEPAフィルターの方が集塵率が上がる為、適応畳数が28畳となります。
Q.一般的な空気清浄機と比べて何が違うのですか?
A.通常の空気清浄機は、空気中のホコリや塵、PM2.5等を集塵することを主な目的としています。ですので菌やウイルスについても「HEPAフィルター」などでフィルターに「集塵」し「吸着」させる方式です。(菌やウイルスはそのままフィルター上に残っています。)また、臭いについても、「活性炭フィルター」などにガス成分を「吸着」させる方式が一般的となっています。一方、フジコーの空気消臭除菌装置は、光触媒フィルターに捕集した菌やウイルスを除去します。また、臭いの元となるガス成分については、光触媒フィルターを通過する際に分解し、消臭します。いずれも「徹底して除去」することが大きな特徴です。
Q.光触媒とはなんですか?
A.光が当たることで、光触媒の表面で強力な酸化力が生まれ、接触する有機化合物や細菌などの有機物質を二酸化炭素と水に分解してしまう物質です。これは、皆さんがよくご存知の光合成とは逆の反応といえます。
※一般的には、光触媒として「酸化チタン」という物質が使われることが多いです。
Q.光触媒の効果に寿命はありますか?
A.フジコーの溶射技術でコーティングされた光触媒は、通常使用においてはがれることはありません。
Q.赤ちゃんや小さなペットがいる部屋で使っても大丈夫ですか?
A.ブルーデオは、ファンで空気を吸引し装置本体内部で消臭・除菌をします。
赤ちゃんやペットが薬剤を吸い込んだり放出物に触れることは一切ございませんので、安心してお使いいただけます。
<フィルター交換について>
・HEPAフィルター(品番MC-M1HP01)…使用環境によって異なりますが、約半年〜1年ごとの交換をお勧めします。掃除機で掃除をしても黒い目詰まりなどの汚れが取れにくくなってきた場合は、HEPAフィルターを交換してください。
・脱臭フィルター(品番MC-M1PF02)…JEMA基準(日本電機工業会規格JEM1467)で6年の寿命を確認していますが、使用環境によって異なります。プレフィルターや集じんフィルターのお手入れをしても脱臭力が戻らない場合は、脱臭フィルターの交換をお勧めします。
※この製品は、日本国内用に設計されています。電源電圧や電源周波数の異なる日本国外では、使用できません。
<リニューアル情報:2023年5月>集じんフィルター(HEPA方式)がHEPAフィルターに変更になり、使用推奨畳数が20畳から28畳になりました。型番がMC-M101からMC-M102に変更となります。
| 商品詳細 | ||||||||||||||||||||||||||||||||||||||||||
|---|---|---|---|---|---|---|---|---|---|---|---|---|---|---|---|---|---|---|---|---|---|---|---|---|---|---|---|---|---|---|---|---|---|---|---|---|---|---|---|---|---|---|
|
【関連ワード】空気清浄機,空気清浄器,家電,新生活,PM2.5,消臭,除菌,空気清浄,浮遊菌,浮遊カビ,カビ,スギ花粉,花粉,白,おしゃれ,ペット臭,ダニ,ブルーディオ,ふじこー,FUJICO,エアロゾル対策
【お客様へ重要なご案内】
*せんべいやクッキーなどの割れやすい商品また缶やパックなどの商品は、取扱・梱包には注意をしておりますが、配送時に多少割れやへこみがあったとしても、商品に問題が無ければ返品・交換はできませんのでご了承願います。
*通常メーカーの定める賞味期限の3分の1以上ある商品を発送いたします。輸入商品などにつきましては、上記より短い期限でもお送りする場合がございます。詳しくはお買い物ガイドをご確認ください。
当サイトでは最新の情報を記載するように努めておりますが、メーカーが告知無しに仕様変更することがございます。
*せんべいやクッキーなどの割れやすい商品また缶やパックなどの商品は、取扱・梱包には注意をしておりますが、配送時に多少割れやへこみがあったとしても、商品に問題が無ければ返品・交換はできませんのでご了承願います。
*通常メーカーの定める賞味期限の3分の1以上ある商品を発送いたします。輸入商品などにつきましては、上記より短い期限でもお送りする場合がございます。詳しくはお買い物ガイドをご確認ください。
当サイトでは最新の情報を記載するように努めておりますが、メーカーが告知無しに仕様変更することがございます。
今が旬イチオシ
レビュー
商品の評価:



-点(0件)
お店の情報
お店の評価:



-点(0件)
連絡・応対
-
配送スピード
-
梱包
-





















